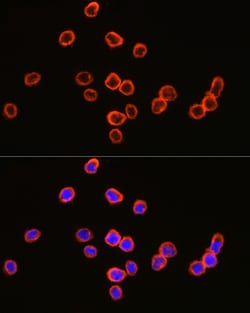

Learn More
Invitrogen™ CD64 Polyclonal Antibody


Description
Immunogen sequence: QVDTTKAVIT LQPPWVSVFQ EETVTLHCEV LHLPGSSSTQ WFLNGTATQT STPSYRITSA SVNDSGEYRC QRGLSGRSDP IQLEIHRGWL LLQVSSRVFT EGEPLALRCH AWKDKLVYNV LYYRNGKAFK FFHWNSNLTI LKTNISHNGT YHCSGMGKHR YTSAGISVTV KELFPAPVLN ASVTSPLLEG NLVTLSCETK LLLQRPGLQL YFSFYMGSKT LRGRNTSSEY QILTARREDS GLYWCEAATE DGNVLKRSPE LELQVLGLQL PTP Positive Samples: LO2, U-937, Mouse liver, Rat liver.

Specifications
Specifications
| Antigen | CD64 |
| Applications | ELISA, Western Blot, Immunocytochemistry |
| Classification | Polyclonal |
| Concentration | 1.48 mg/mL |
| Conjugate | Unconjugated |
| Formulation | PBS with 50% glycerol and 0.05% ProClin 300; pH 7.3 |
| Gene | FCGR1A |
| Gene Accession No. | P12314, P26151 |
| Gene Alias | AI323638; AV092959; CD64; CD64 antigen; CD64A; Fc fragment of IgG high affinity Ib receptor; Fc fragment of IgG receptor Ia; Fc fragment of IgG, high affinity Ia, receptor (CD64); Fc fragment of IgG, high affinity Ia, receptor for (CD64); Fc fragment of IgG, high affinity Ib, receptor for (CD64); Fc gamma receptor; Fc gamma receptor Ia; Fc receptor, IgG, high affinity I; Fcg1; Fc-gamma receptor 1; Fc-gamma receptor I A1; Fc-gamma RI; Fc-gamma RIA; FcgammaRI; FcgammaRIa; Fcgr1; FCGR1A; Fcgr1b; FcgRI; FCRI; FLJ18345; high affinity IgG Fc receptor, subunit beta; high affinity immunoglobulin gamma Fc receptor I; high-affinity immunoglobulin gamma Fc receptor I; IGFR1; IgG Fc receptor I; IgG high affinity Fc receptor; IGGHAFC; RP11-196G18.2 |
| Gene Symbols | Fcgr1, FCGR1A |
| Show More |
By clicking Submit, you acknowledge that you may be contacted by Fisher Scientific in regards to the feedback you have provided in this form. We will not share your information for any other purposes. All contact information provided shall also be maintained in accordance with our Privacy Policy.